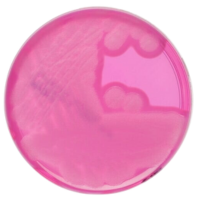
Myp_Agar_gotowa_pożywka_do_oznaczania_Bacillus_cereus_Bestlabs.png

MYP Agar (Mannitol Egg Yolk Polymyxin Agar) gotowa pożywka do oznaczania Bacillus cereus
• Opakowanie: 10 szt.
• Płytka: 90 mm.
• Do oznaczania Bacillus cereus.
Cena
zawiera 23% VAT, bez kosztów dostawy
Cena netto
36,42 zł
bez 23% VAT i kosztów dostawy
Dostępność
Na magazynie (czas dostawy 3-5 dni)
Wysyłka
Zgodnie z informacją o stanie magazynowym
Termin dostawy jest szacowany na podstawie dostępności produktu u poroducenta, termin dostawy dla towaru dostępnego wynosi 3 do 5 dni roboczych od daty zaksięgowania wpłaty, w przypadku dodatkowych pytań skontaktuj się poprzez czat z naszym specjalistą
Dostawa
Koszt dostawy uzależniony od wartości zamówienia, dla zamowień powyżej 800,00 netto wynosi 0 zł, standardowy koszt dostawy 35,00 zł netto
Producent
Oxoid
 Opis
Opis
MYP Agar to selektywna pożywka mikrobiologiczna opracowana do izolacji i oznaczania Bacillus cereus w różnych próbkach, takich jak żywność, pasza i próbki środowiskowe. Dzięki swojej precyzyjnej formule pozwala na skuteczne różnicowanie Bacillus cereus od innych mikroorganizmów.
Cechy i zalety produktu
Skuteczna identyfikacja
- Selektywne właściwości pozwalają na izolację Bacillus cereus w obecności innych bakterii.
- Zapewnia wyraźne różnicowanie dzięki charakterystycznym koloniom.
Gotowość do użycia
- Gotowe płytki agarowe eliminują konieczność przygotowywania podłoża, co oszczędza czas i zmniejsza ryzyko błędów.
- Standardowa wielkość płytki: 90 mm – kompatybilna z procedurami mikrobiologicznymi w większości laboratoriów.
Wydajne pakowanie
- Opakowanie: 10 szt. – idealne rozwiązanie dla laboratoriów o średnim zapotrzebowaniu na analizy mikrobiologiczne.
Specyfikacja produktu
- Typ podłoża: MYP Agar.
- Do oznaczania: Bacillus cereus.
- Płytka: 90 mm.
- Opakowanie: 10 szt.
Zastosowanie
MYP Agar znajduje zastosowanie w:
- Kontroli jakości w przemyśle spożywczym – wykrywanie Bacillus cereus w produktach żywnościowych i paszach.
- Badaniach środowiskowych – identyfikacja Bacillus cereus w próbkach środowiskowych.
- Diagnostyce mikrobiologicznej – analiza próbek pod kątem obecności Bacillus cereus.
Dlaczego warto wybrać MYP Agar?
Kluczowe korzyści:
- Precyzja – skuteczne oznaczanie Bacillus cereus dzięki selektywnym właściwościom.
- Wygoda – gotowe płytki eliminują konieczność czasochłonnych przygotowań.
- Efektywność – opakowanie 10 sztuk spełnia potrzeby rutynowych analiz laboratoryjnych.
MYP Agar to niezawodne narzędzie dla laboratoriów mikrobiologicznych, które poszukują precyzyjnych i skutecznych rozwiązań do oznaczania Bacillus cereus.
W powyższym linku znajdą Państwo bazę aktualnych certyfikatów firmy OXOID. Wystarczy wpisać numer LOT zamówionej przez Państwa partii, w celu uzyskania odpowiedniego certyfikatu.
 Koszty dostawy
Cena netto, nie zawiera podatku
Koszty dostawy
Cena netto, nie zawiera podatku
Kraj wysyłki:
darmowa i wygodna wysyłka
już od 800 zł netto
Najwyższa jakość
produktów potwierdzona certyfikatami
Zakupy 24h na dobę
wygodne i bezpieczne
bezpłatna konsultacja
z ekspertem online